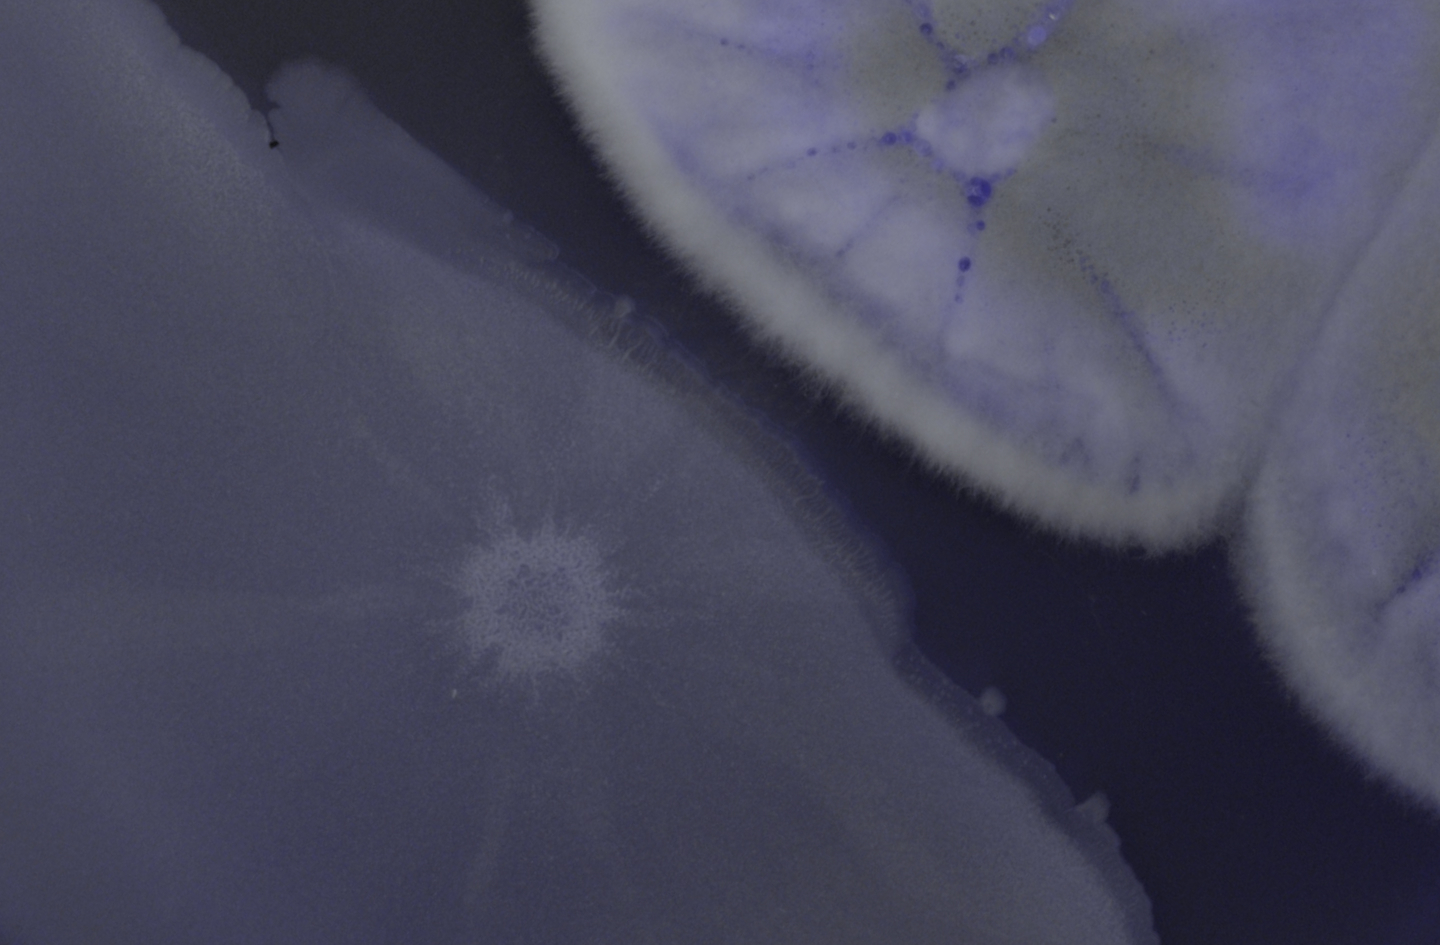
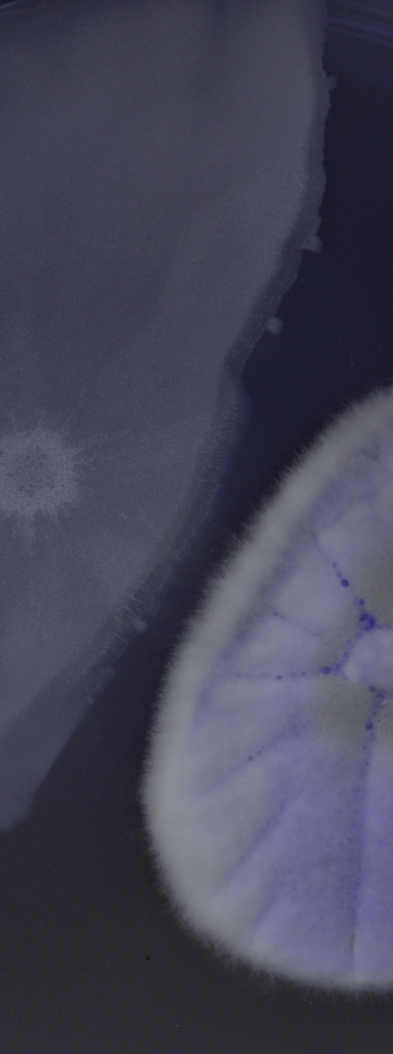

How Syngenta digitally transformed detection of active compounds using AI
Scaling up accurate high-throughput screening is often a challenge. Learn how Syngenta managed to automate their assay by combining state-of-the-art AI and analytics with high-resolution, scalable time-lapse imaging.